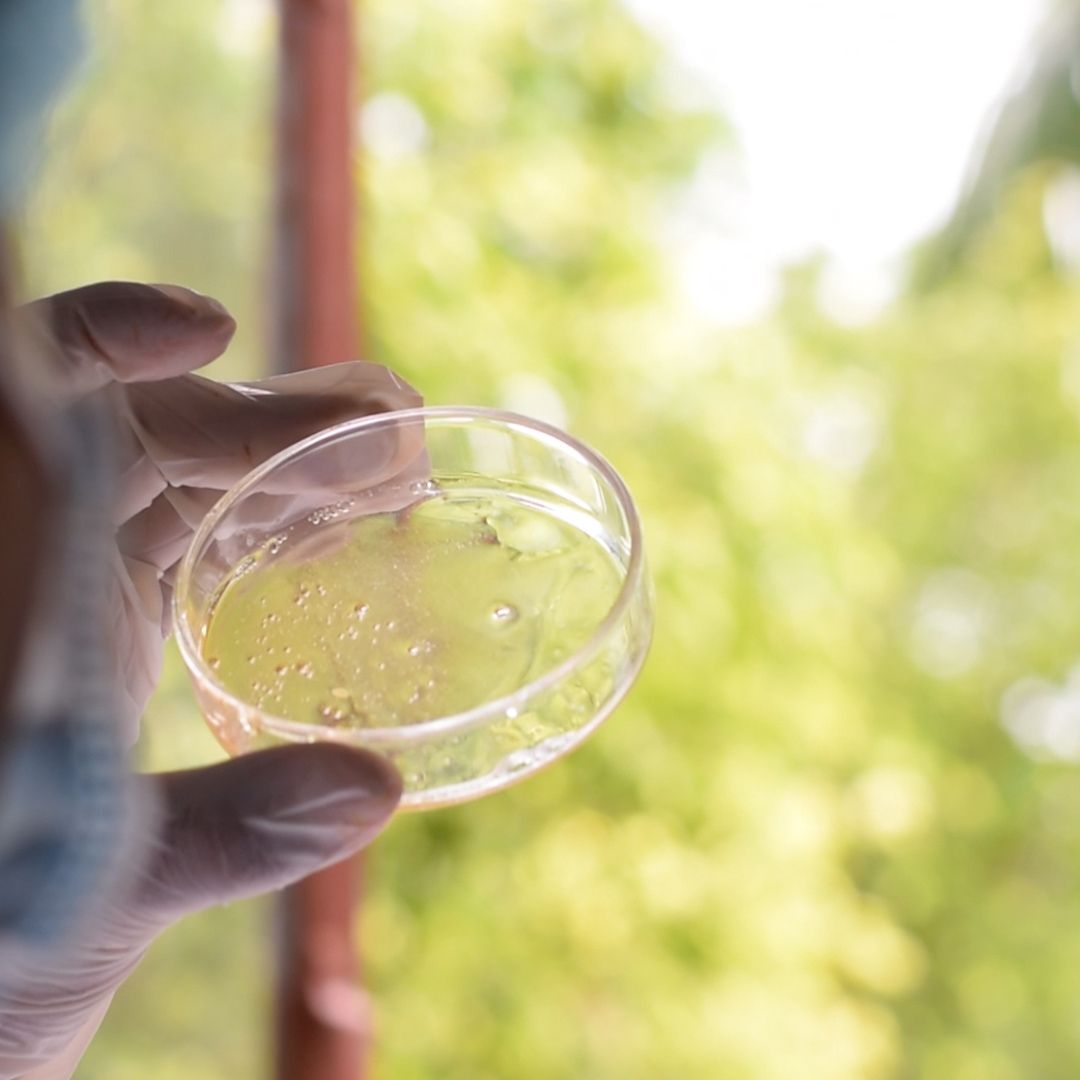

Online Visit
100% Chemical & Preservative free
Makers of Skin, Food, Health & Wellness Raw material & Private Label products
Certified Organic with GMP Standards
Here’s what we do to make different products and their ingredients to ensure Pure -Effective product made completely free from Chemicals and Preservatives.
View the detailed catalogue below and feel free to connect with us.